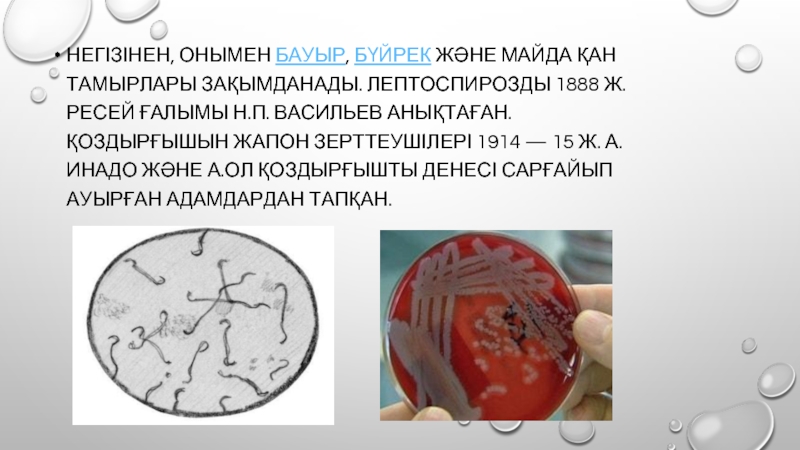

- Главная
- Разное
- Дизайн
- Бизнес и предпринимательство
- Аналитика
- Образование
- Развлечения
- Красота и здоровье
- Финансы
- Государство
- Путешествия
- Спорт
- Недвижимость
- Армия
- Графика
- Культурология
- Еда и кулинария
- Лингвистика
- Английский язык
- Астрономия
- Алгебра
- Биология
- География
- Детские презентации
- Информатика
- История
- Литература
- Маркетинг
- Математика
- Медицина
- Менеджмент
- Музыка
- МХК
- Немецкий язык
- ОБЖ
- Обществознание
- Окружающий мир
- Педагогика
- Русский язык
- Технология
- Физика
- Философия
- Химия
- Шаблоны, картинки для презентаций
- Экология
- Экономика
- Юриспруденция
Лептоспироз презентация
Содержание
- 1. Лептоспироз
- 2. ЛЕПТОСПИРОЗ (ГРЕК. LEPTOS — ЖІҢІШКЕ ЖӘНЕ ГРЕК. SPEІRA — ИРЕКШЕ, БҰРАМА; ГРЕК. OSІS — АУРУ) —
- 3. НЕГІЗІНЕН, ОНЫМЕН БАУЫР, БҮЙРЕК ЖӘНЕ МАЙДА ҚАН ТАМЫРЛАРЫ ЗАҚЫМДАНАДЫ. ЛЕПТОСПИРОЗДЫ
- 4. ЛЕПТОСПИРА БАКТЕРИЯЛАРЫ — ТАСЫМАЛДАУШЫ ЖАНУАРЛАРДЫҢ БҮЙРЕГІНІҢ МАЙДА
- 5. ЖІКТЕЛУІ ҚАЗІРГІ КЕЗДЕ БҰЛ ДЕРТТІ АУРУ ҚОЗДЫРҒЫШЫНЫҢ
- 8. У 15-50% БОЛЬНЫХ – ПОЛИМОРФНАЯ ЭКЗАНТЕМА (КОРЕПОДОБНАЯ,
- 9. ПРИЗНАКИ ТЯЖЕЛОГО ЛЕПТОСПИРОЗА НАЛИЧИЕ ЖЕЛТУХИ, ЗУДА КОЖИ
- 10. ОСНОВНЫМИ ПРИЧИНАМИ СМЕРТИ У БОЛЬНЫХ ЛЕПТОСПИРОЗОМ
- 11. ДИАГНОСТИКА ОАК (НЕЙТРОФИЛЬНЫЙ ЛЕЙКОЦИТОЗ, ЗНАЧИТЕЛЬНОЕ ПОВЫШЕНИЕ СОЭ)
- 12. ЭТИОТРОПНАЯ ТЕРАПИЯ БЕНЗИЛПЕНИЦИЛЛИН 6-12
- 13. СПЕЦИФИЧЕСКОЙ ВАКЦИНАЦИИ ПУТЁМ ВВЕДЕНИЯ УБИТОЙ ЛЕПТОСПИРОЗНОЙ ВАКЦИНЫ
- 14. БУДЬТЕ ЗДОРОВЫ!
Слайд 1
Кафедра: Бала жұқпалы аурулар
Тақырыбы: Липтоспироз
Орындаған: Ордабек.Е
Факультет:Педиатрия
Топ: 603-1
Тексерген:Джумабекова.А.Т
Слайд 2ЛЕПТОСПИРОЗ (ГРЕК. LEPTOS — ЖІҢІШКЕ ЖӘНЕ ГРЕК. SPEІRA — ИРЕКШЕ, БҰРАМА; ГРЕК. OSІS — АУРУ) — АДАМДАРДА, СҮТҚОРЕКТІЛЕРДЕ ЖӘНЕ ҚҰСТАРДА
ҚОЗДЫРҒЫШЫ — СПИРАЛЬ ПІШІНДІ ЛЕПТОСПИРА БАКТЕРИЯЛАРЫ.
Слайд 3НЕГІЗІНЕН, ОНЫМЕН БАУЫР, БҮЙРЕК ЖӘНЕ МАЙДА ҚАН ТАМЫРЛАРЫ ЗАҚЫМДАНАДЫ. ЛЕПТОСПИРОЗДЫ 1888 Ж. РЕСЕЙ ҒАЛЫМЫ
Слайд 4ЛЕПТОСПИРА БАКТЕРИЯЛАРЫ — ТАСЫМАЛДАУШЫ ЖАНУАРЛАРДЫҢ БҮЙРЕГІНІҢ МАЙДА ӨЗЕКШЕЛЕРІНДЕ ӨСІП-ӨНІП САҚТАЛАДЫ, СЫРТҚЫ
Слайд 5ЖІКТЕЛУІ
ҚАЗІРГІ КЕЗДЕ БҰЛ ДЕРТТІ АУРУ ҚОЗДЫРҒЫШЫНЫҢ ТҮРЛЕРІНЕ, КЛИНИКАЛЫҚ БЕЛГІЛЕРІНЕ, АУРУ АҒЫМЫНА
ИНТЕРОГЕМОРРАГИЯЛЫҚ ЛЕПТОСПИРОЗ (ДЕНЕ САРҒАЯДЫ) НЕМЕСЕ ВАСИЛЬЕВ-ВЕЙЛЬ АУРУЫ ДЕП АТАЛАДЫ;
КАНИКОЛ ЛЕПТОСПИРОЗ (НЕМЕСЕ ПОМОН) (ДЕНЕДЕ ҚАН ҚҰЙЫЛУ БАЙҚАЛАДЫ);
“СУ ҚЫЗБАСЫ” ДЕП АТАЛАТЫН ЖЕҢІЛ ӨТЕТІН (ДЕНЕ САРҒАЙМАЙДЫ) ТҮРІ.
Слайд 6
ИНКУБАЦИЯЛЫҚ КЕЗЕҢІ 2-30 КҮН.
БІРІНШІДЕН ДЕНЕ ҚЫЗБАСЫ БАСТАЛАДЫ (39 — 40°С), ӨЗІ ҚАЛТЫРАП, БҰЛШЫҚ ЕТТЕРІ ҚАТТЫ АУЫРАДЫ; КӨЗІ ҚЫЗАРАДЫ; ЛОҚСЫП ҚҰСЫП, ҰЙҚЫСЫ ҚАШАДЫ. АУРУ АСҚЫНҒАНДА САНДЫРАҚТАП, МҰРНЫНАН ҚАН КЕТІП, ЕРІН, МҰРЫН АЙНАЛАСЫНА ҰШЫҚ ШЫҒАДЫ. БАУЫРЫ ІСІНЕДІ, ДЕНЕГЕ БӨРТПЕ ШЫҒАДЫ, ДЕНЕНІҢ САРҒАЮЫ БАЙҚАЛАДЫ. АУРУДЫ ДЕР КЕЗІНДЕ ЕМДЕМЕСЕ, АДАМДАРДЫҢ ӨЛІП КЕТУІ (ӘСІРЕСЕ, ЖАСЫ КЕЛГЕН) ДЕ МҮМКІН. АЛ САРҒАЙМАЙ, ЖЕҢІЛ ТҮРІМЕН НАУҚАСТАНҒАНДА 6 — 12 АПТАДАН КЕЙІН ТОЛЫҚ АЙЫҒЫП КЕТЕДІ. АУРУ ДИАГНОЗЫ ЛАБАРАТОРИЯЛЫҚ ӘДІСТЕРМЕН АНЫҚТАЛАДЫ.
Слайд 8У 15-50% БОЛЬНЫХ – ПОЛИМОРФНАЯ ЭКЗАНТЕМА (КОРЕПОДОБНАЯ, КРАСНУХОПОДОБНАЯ, СКАРЛАТИНОПОДОБНАЯ)
ДИФФУЗНОЕ ПОРАЖЕНИЕ МИОКАРДА
ГЕПАТОМЕГАЛИЯ, РЕЖЕ СПЛЕНОМЕГАЛИЯ
ОРГАННЫЕ ПОРАЖЕНИЯ (ПОЧКИ, ЛЕГКИЕ, ПЕЧЕНЬ, ЦНС И ДР.)
Слайд 9ПРИЗНАКИ ТЯЖЕЛОГО ЛЕПТОСПИРОЗА
НАЛИЧИЕ ЖЕЛТУХИ, ЗУДА КОЖИ (С 3-5 ДНЯ БОЛЕЗНИ) (В
ГЕМОРРАГИЧЕСКИЙ СИНДРОМ (ПЕТЕХИАЛЬНАЯ СЫПЬ, КРОВОИЗЛИЯНИЯ НА МЕСТЕ ИНЪЕКЦИЙ, НОСОВЫЕ И ДЕСНЕВЫЕ КРОВОТЕЧЕНИЯ, КРОВОИЗЛИЯНИЯ В СКЛЕРЫ)
ЛЕПТОСПИРОЗНЫЙ МЕНИНГИТ (ДО 1/3 СЛУЧАЕВ): МЕНИНГЕАЛЬНЫЕ ЗНАКИ, В ЛИКВОРЕ ЦИТОЗ ДО 500 КЛ, ЧАЩЕ ЛИМФОЦИТАРНЫЙ, С УМЕРЕННО ПОВЫШЕННЫМ БЕЛКОМ И НОРМАЛЬНОЙ ГЛЮКОЗОЙ
НЕФРОПАТИЯ (ОЛИГОАНУРИЯ, МОЧЕВОЙ СИНДРОМ, ПРОТЕИНУРИЯ, АЗОТЕМИЯ) ВПЛОТЬ ДО ОПН (ПРИ ЭТОМ ХАРАКТЕРНО ОТСУТСТВИЕ ОТЕКОВ И ГИПЕРТЕНЗИИ)
Слайд 10 ОСНОВНЫМИ ПРИЧИНАМИ СМЕРТИ У БОЛЬНЫХ ЛЕПТОСПИРОЗОМ ЯВЛЯЛИСЬ
ИТШ
ОСТРАЯ ПОЧЕЧНО-ПЕЧЕНОЧНАЯ НЕДОСТАТОЧ-НОСТЬ В
Слайд 11ДИАГНОСТИКА
ОАК (НЕЙТРОФИЛЬНЫЙ ЛЕЙКОЦИТОЗ, ЗНАЧИТЕЛЬНОЕ ПОВЫШЕНИЕ СОЭ)
ОАМ (ПРОТЕИНУРИЯ, ГИАЛИНОВЫЕ И ЗЕРНИСТЫЕ ЦИЛИНДРЫ,
Б\Х АК (ПОВЫШЕНИЕ БИЛИРУБИНА, ЩФ, МОЧЕВИНЫ, КРЕАТИНИНА, И ДР.), КОАГУЛОГРАММА
ТЕМНОПОЛЬНАЯ МИКРОСКОПИЯ КРОВИ (В ПЕРВЫЕ ДНИ БОЛЕЗНИ), ОСАДКА МОЧИ (С 7-8 ДНЯ БОЛЕЗНИ), ЛИКВОРА
БАКТЕРИОЛОГИЧЕСКИЙ ПОСЕВ КРОВИ, МОЧИ, ЛИКВОРА
СЕРОЛОГИЧЕСКИЕ ИССЛЕДОВАНИЯ (Р-ИЯ МИКРОАГГЛЮТИНАЦИИ, РПГА, РНИФ, ИФА)
ПЦР- ДИАГНОСТИКА
БИОЛОГИЧЕСКИЙ МЕТОД (ИСПОЛЬЗУЕТСЯ РЕДКО)
Слайд 12 ЭТИОТРОПНАЯ ТЕРАПИЯ
БЕНЗИЛПЕНИЦИЛЛИН 6-12 МЛН ЕД/СУТ, ПРИ МЕНИНГИТЕ ДО
АМПИЦИЛЛИН 0,5-1,0 Г Х 4 РАЗА/СУТ В/В
ЦЕФТРИАКСОН 1,0 Г Х 1 РАЗ/СУТ В/В